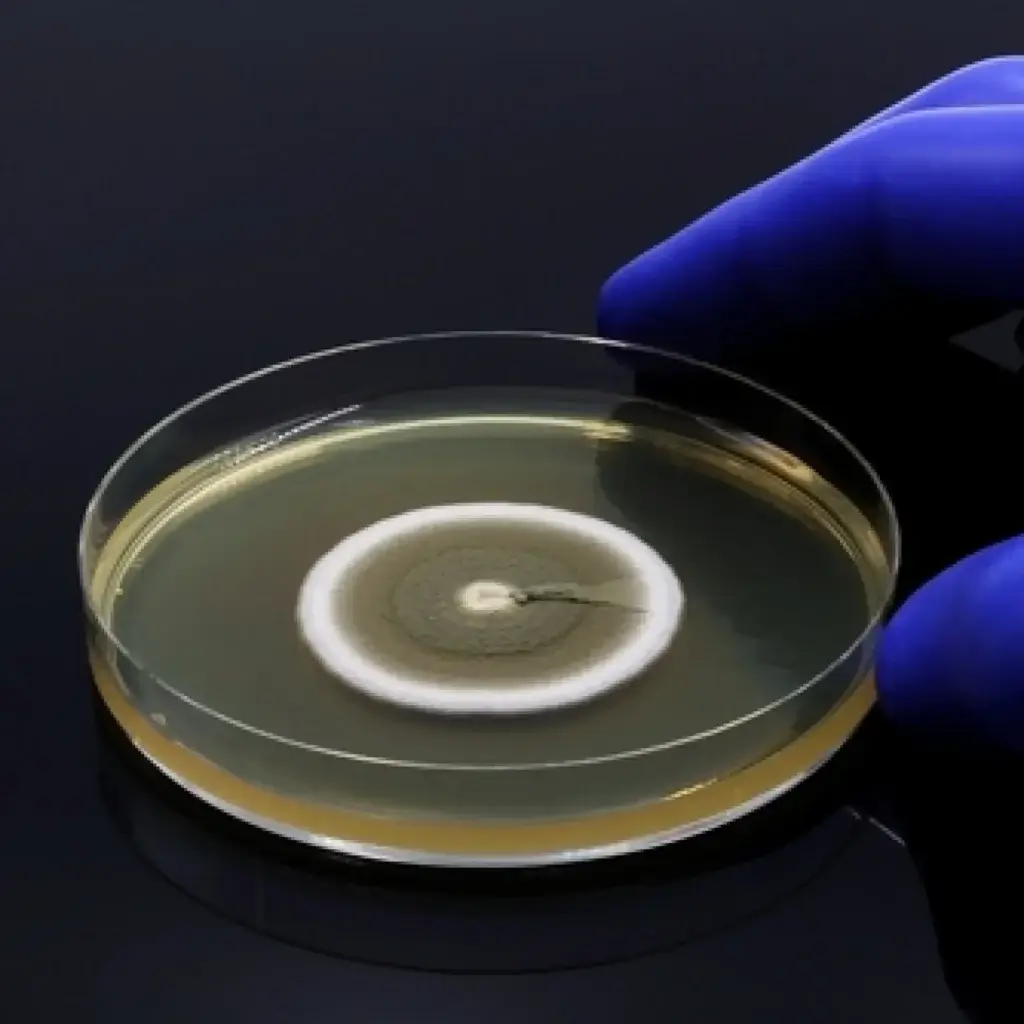
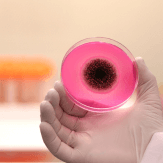

Textile Testing Lab
What is textile testing?
Objectives of textile or fabric testing
Different types of textile testing
How to choose the right textile tests
Antimicrobial textile and fabric testing
Test methods for textiles


- JIS L 1902

- ISO 20743: 2013

- ASTM E2149: 2020

- AATCC 147: 2004

Organisms tested in our textile testing laboratory

Bacteria
Staphylococcus aureus (ATCC 6538P), Klebsiella pneumoniae (ATCC 4352), Escherichia coli (ATCC 8739), Pseudomonas aeruginosa (ATCC 15442), Enterococcus hirae (ATCC 10541), MRSA (ATCC 33591), Salmonella enterica (ATCC 10708)

Virus
SARS CoV-2, Beta Coronavirus (OC-43) (ATCC VR-1558) , Human Coronavirus (229E) (ATCC VR-740) , Influenza A (H1N1) (ATCC VR-1469) Influenza A (H3N2) (ATCC VR-1679), Adenovirus, Norovirus, Poliovirus, Vaccinia virus, Feline Calicivirus

Fungi
Candida albicans (MTCC 3017), Aspergillus niger (ATCC-16888)

Insects
Culicidae family, Cimex lectularius, Arachnid family and Pyroglyphidae family
Scope of textile products tested at MIS
Regulatory requirements and ISO
certifications for textile testing
Textiles must be tested in accordance with various regulatory standards to ensure compliance and international market acceptance. These regulations often vary depending on the region, industry and the intended use of the product. For example, in European countries, the European Union’s REACH (Registration, Evaluation, Authorisation and Restriction of Chemicals) for chemical safety governs the testing of textile products, while in the United States, CPSIA (Consumer Product Safety Improvement Act) for children’s products takes over the responsibility of textile products safety for children specifically.
ISO certifications, such as ISO 9001 for quality management and ISO 14001 for environmental management, respectively, play a crucial role in ensuring that textile products meet international standards. For specific antimicrobial properties of textiles, certifications such as ISO 20743 or ISO 18184 are widely recognised. Compliance with these standards assures that textiles have been rigorously tested and are guaranteed to meet global standards for safety, performance and sustainability.
Importance of textile and fabric testing
Quality assurance
Ensures that textiles meet specified quality standards and customer expectations.
Regulatory compliance
Verifies that textiles comply with national and international safety standards and regulations.
Innovation and development
Enables manufacturers to experiment with new antimicrobial formulations which leads to innovation.
Market competitiveness
Compliance helps manufacturers differentiate their products in a competitive market.
Risk management
Reduces the likelihood of product failures, legal liabilities, damage to brand reputation, and costly returns.
Advantages of antimicrobial testing on textile products
The current market has witnessed a drift from ordinary textiles to antimicrobial textiles. This shift has led to the development of antimicrobial-treated clothing materials to meet customer needs. The development of these textile products must be followed by rigorous testing to ensure their efficacy, quality and reliability against harmful microbes. In essence, antimicrobial testing of textiles plays an important role in product development.
Why Trust MIS Textile
Testing Laboratory?
Consult our experts for further information and to discuss quotations for testing services. Our consultation experts guide you through challenges and the best possible solutions for high-quality product development.
Other Industries
Frequently Asked Questions
Ready to test your product?